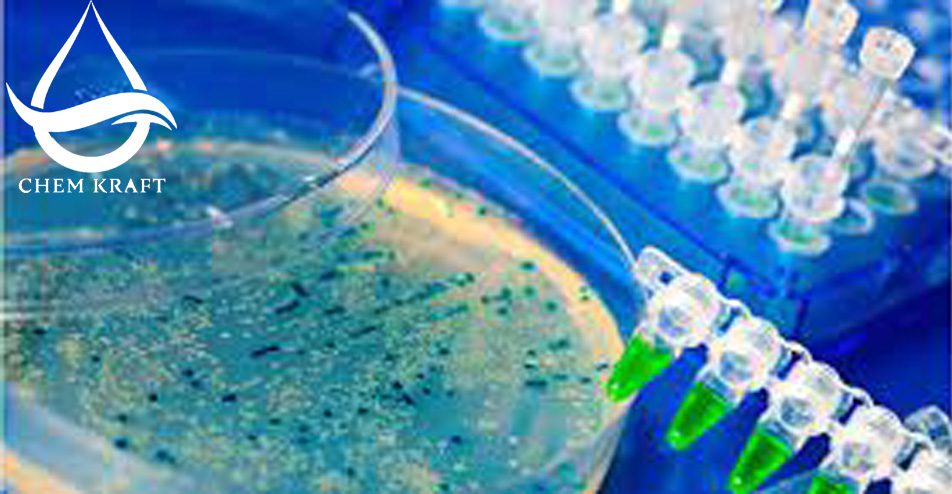
میکروب کش

بایوسیاد (میکروب کش) چیست :
بایوساید (میکروب کش) در صنعت کاغذ نقش مهمی در جامعه ما ایفا می کند و انواع مختلفی از محصولات کاغذی را در اختیار ما قرار می دهد. با این حال، این صنعت در جلوگیری از رشد میکروارگانیسم ها بر روی سطوح کاغذی با چالش قابل توجهی مواجه است. برای رفع این مشکل، معمولاً از عوامل بایوساید در صنعت کاغذ استفاده می شود.
1) میکروب کش DST794
عوامل بایوساید مواد شیمیایی هستند که برای از بین بردن یا مهار رشد میکروارگانیسم ها از جمله باکتری ها، قارچ ها و
جلبک ها طراحی شده اند.
در این مقاله، انواع مختلف عوامل بایوساید (میکروب کش) مورد استفاده در صنعت کاغذ، عملکرد آنها و تأثیر آنها بر محیط زیست و
سلامت انسان را بررسی خواهیم کرد.
انواع:
یکی از عوامل بایوساید (میکروب کش) رایج در صنعت کاغذ، کلر است. ترکیبات کلر مانند دی اکسید کلر و هیپوکلریت ها در کنترل رشد میکروبی روی سطوح کاغذ موثر هستند. این عوامل بایوساید با ایجاد اختلال در دیواره سلولی و غشای میکروارگانیسم ها عمل می کنند که منجر به تخریب آنها می شود. بایوسیدهای مبتنی بر کلر به دلیل خواص ضد میکروبی وسیع الطیف، مقرون به صرفه بودن و در دسترس بودن، محبوب هستند.
یکی دیگر از عوامل بایوساید مهم مورد استفاده در صنعت کاغذ، ترکیبات آمونیوم چهارتایی (QACs) است.
این ترکیبات حاوی اتم های نیتروژن با بار مثبت هستند که می توانند به غشای سلولی میکروارگانیسم ها با بار منفی متصل
شوند و باعث لیز سلولی و مرگ شوند.
QAC ها به دلیل سمیت و پایداری کم تـرجیح داده مـی شوند، اما در برابر انواع خـاصی از میکروارگانیسم ها در مـقایسه با
بایوسیادهای مبتنی بر کلر کمتر موثر هستند.
علاوه بر کلر و QACs، سایر عوامل بیوسید مورد استفاده در صنعت کاغذ شامل اسیدهای آلی مانند اسید سوربیک و اسید
بنزوئیک و بیوسیادهای معدنی مانند نانوذرات نقره هستند.
اسیدهای آلی با ایجاد اختلال در فرآیندهای متابولیک در میکروارگانیسمها عمل میکنند در حالی که نانوذرات نقره یونهای
نقره را آزاد میکنند که برای طیف وسیعی از میکروارگانیسمها سمی هستند.
عملکرد:
عملکرد اولیه عوامل بایوساید (میکروب کش) در صنعت کاغذ، جلوگیری از رشد میکروبی است که می تواند منجر به تغییر رنگ کاغذ، بو،
آسیب فیزیکی و انتشار ترکیبات سمی شود.
رشد میکروبی روی سطوح کاغذ می تواند در مراحل مختلف فرآیند تولید کاغذ از جمله ذخیره سازی، حمل و نقل و استفاده رخ دهد.
عوامل بایوساید (میکروب کش) به کاغذ اضافه می شوند یا به عنوان پوشش برای مهار رشد میکروبی و حفظ کیفیت و زیبایی محصولات کاغذی اعمال می شوند.
نگرانی های زیست محیطی:
علیرغم مزایای آنها، استفاده از عوامل بایوساید در صنعت کاغذ باعث ایجاد نگرانی های زیست محیطی می شود.
این مواد شیمیایی می توانند اثرات منفی بر روی اکوسیستم های آبی داشته باشند زمانی که زباله های کاغذی حاوی
بایوسیدها به بدنه های آبی تخلیه می شوند.
عوامل بایوساید می توانند در محیط انباشته شوند و به ماهی ها، دوزیستان و دیگر موجودات آبزی آسیب برسانند.
علاوه بر این انتشار میکروارگانیسمهای مقاوم به بیوساید در محیط ممکن است منجر به ظهور سویههای مقاوم به
آنتیبیوتیک شود که تهدیدی برای سلامت انسان است.
برای کاهش این نگرانی های زیست محیطی، اتخاذ شیوه های پایدار برای صنعت کاغذ ضروری است. این شامل استفاده از عوامل زیست کش جایگزین و کمتر سمی مانند ترکیبات ضد میکروبی طبیعی مشتق شـده از گیاهان یا میکروب ها مـی شود. علاوه بر این، اجرای فرآیندهای موثر تصفیه فاضلاب می تواند به حذف یا کاهش غلظت عوامل بیوساید قبل از تخلیه آب در محیط کمک کند.
نتیجه:
در نتیجه، عوامل زیست کش با جلوگیری از رشد میکروبی روی سطوح کاغذ، نقش مهمی در صنعت کاغذ بازی می کنند. استفاده از عوامل بایوساید مانند کلر، ترکیبات آمونیوم چهارتایی و اسیدهای آلی به حفظ کیفیت و یکپارچگی محصولات کاغذی کمک می کند.
با این حال استفاده از آنها نگرانی های زیست محیطی را در مورد تأثیر آنها بر اکوسیستم های آبی و ظهور بالقوه میکروارگانیسم های مقاوم به آنتی بیوتیک ایجاد می کند.
بنابراین صنعت کاغذ بـاید یافتن جایگزینهای پایدارواجرای تصفیه فاضلاب مناسب را در اولویت قرار دهـد تا اثرات منفی زیستمحیطی و بهداشتی مرتبط با استفاده از عوامل زیستکش را به حداقل بـرساند.